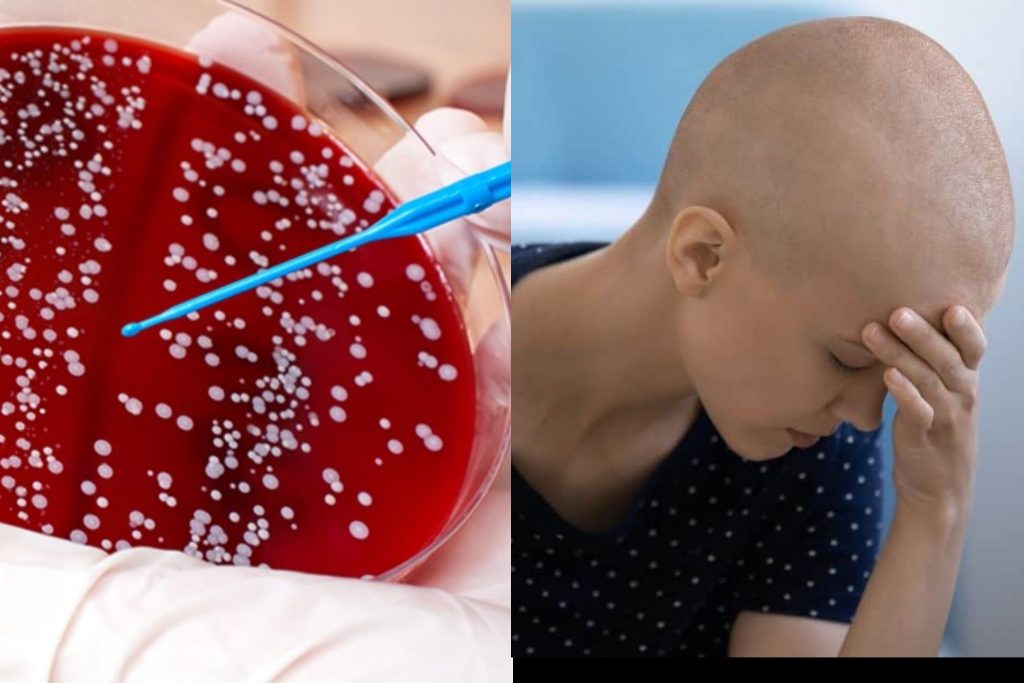

Posted inEntertainment
තායිලන්තයේදි අහිමි වූ Miss Universe Sri Lanka කිරුල නැවතත් එයාට ලැබිලා
Miss Universe Sri Lanka 2025 ලිහාෂා ලින්ඩ්සේ-වයිට් තය්ලන්තයේ ටැක්සියක අමතක වූ ඇගේ කිරුල සහ තරගය වෙනුවෙන් සූදානම් කරගත් අඳුරු පාට ගවුම තය්ලන්ත සංචාරක පොලිසිය විසින් ඉක්මනින් සොයාගෙන ඇයට ආපසු…